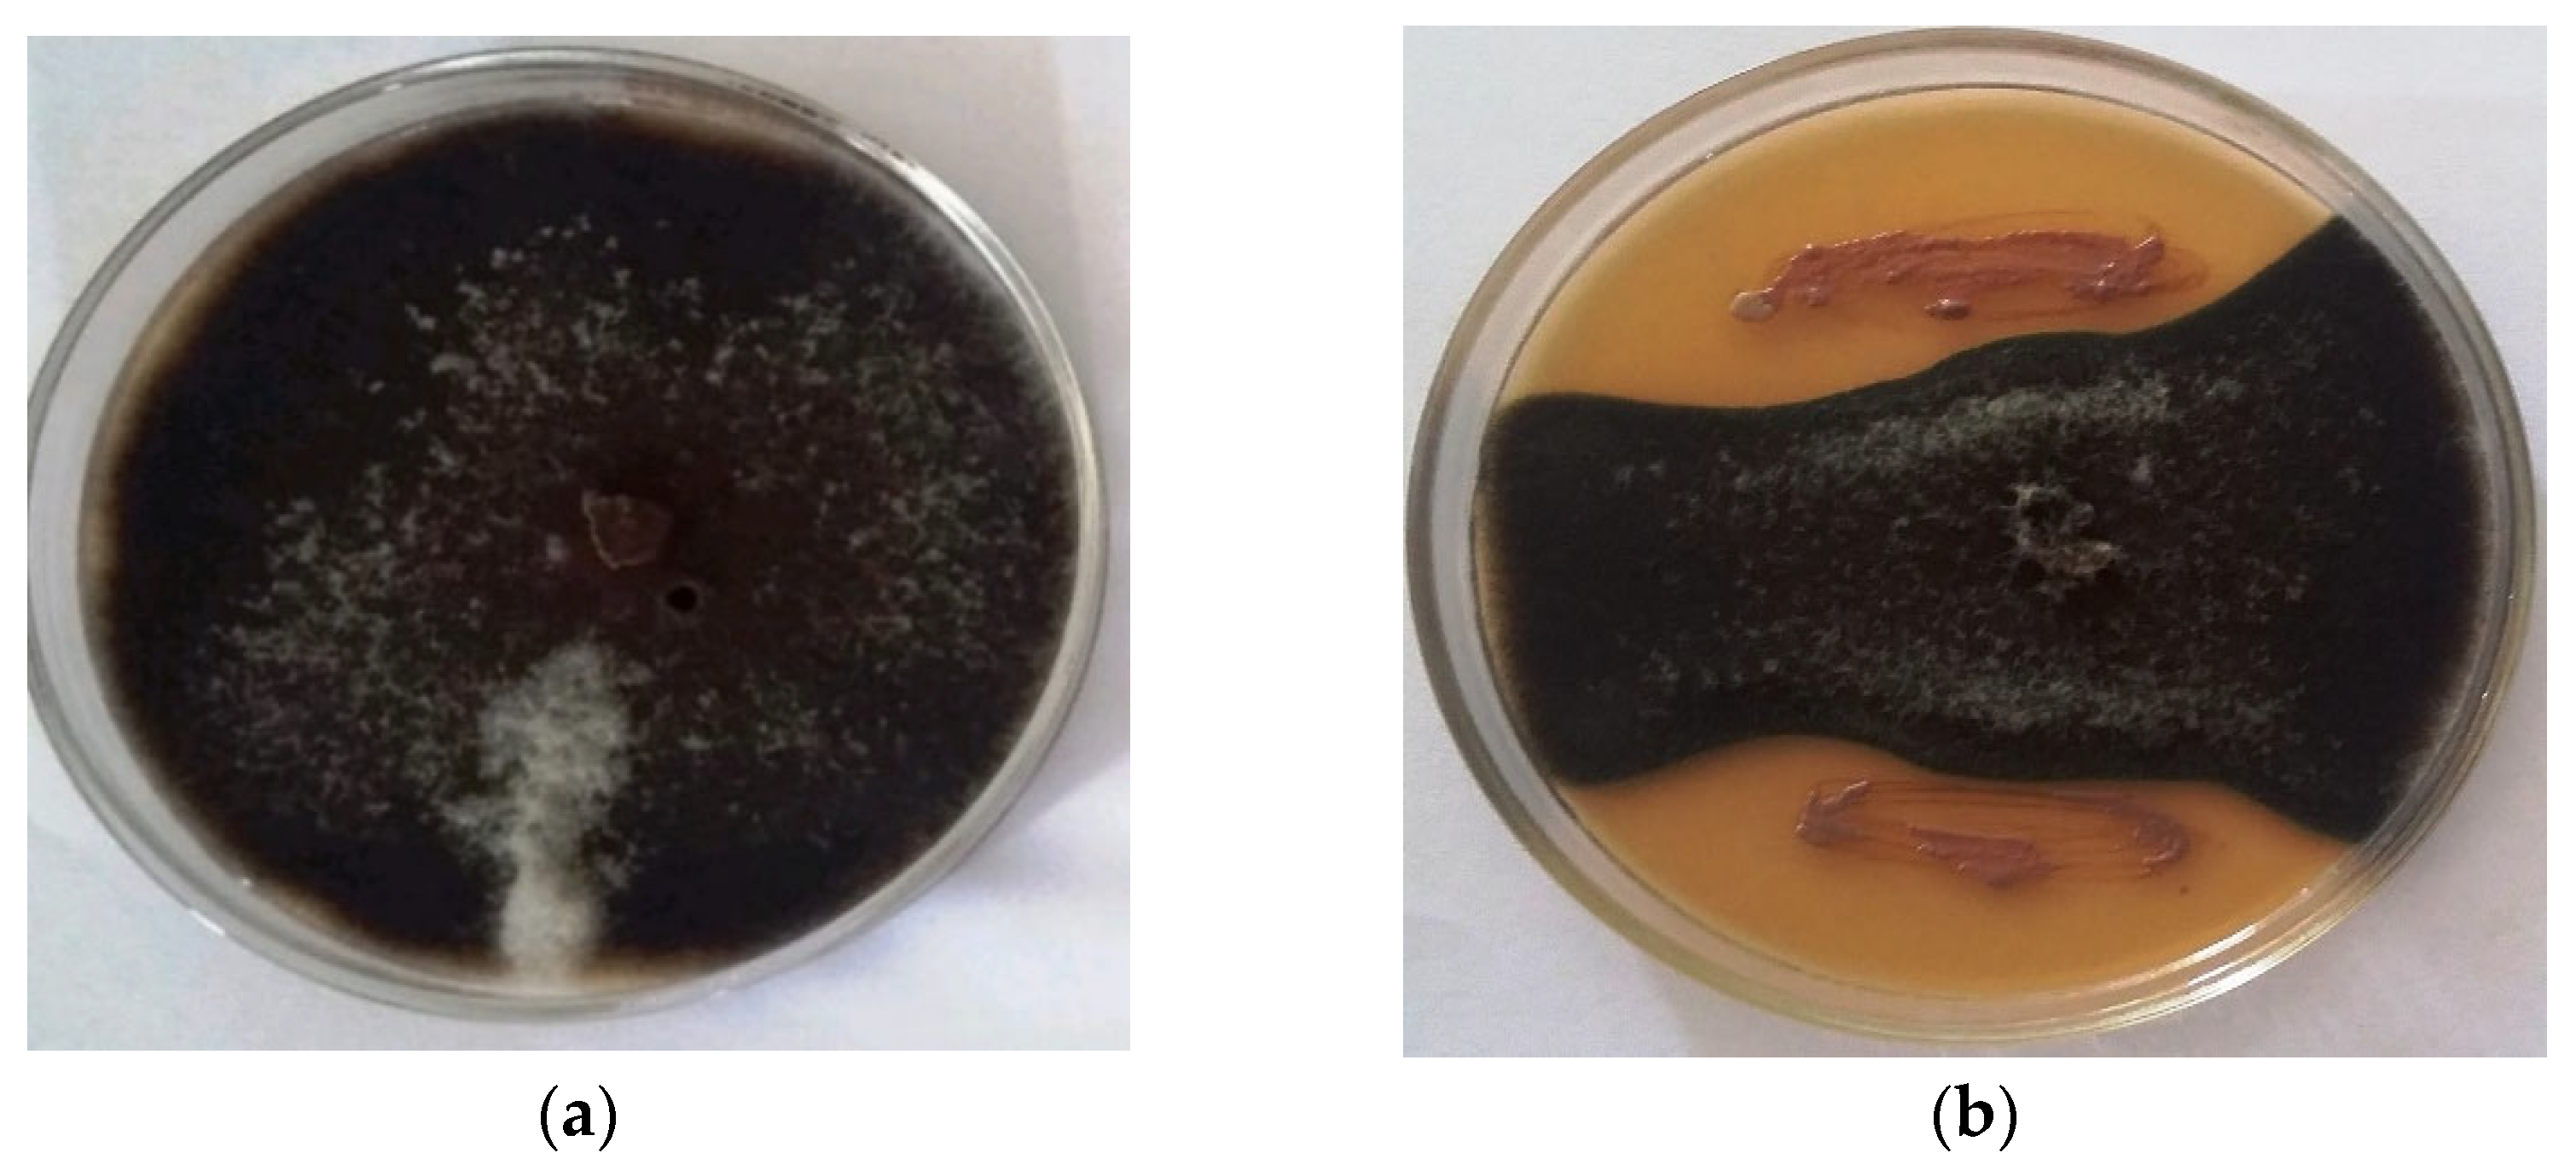

A Novel Bacillus safensis-Based Formulation along with Mycorrhiza Inoculation for Controlling Alternaria alternata and Simultaneously Improving Growth, Nutrient Uptake, and Steviol Glycosides in Stevia rebaudiana under Field Conditions
Abstract
:1. Introduction
2. Results
2.1. Biocontrol Traits
2.2. Impact of Bioformulation on Growth of S. Rebaudiana
2.3. Impact of Bioformulations on Biochemical Aspects of S. rebaudiana
2.4. Stevioside Content
2.5. Impact of P-WBF and Mycorrhiza on Nutrient Uptake in S. rebaudiana
2.6. Quantitative Analysis of UGT85C2, UGT74G1, and UGT76G1 Genes in Steviol Glycoside Biosynthesis
2.7. Impact of Bioformulation on Soil Health
3. Discussion
4. Materials and Methods
4.1. Microorganisms, Phytopathogen, and Seedling Collection
4.2. Biocontrol Characteristics of Isolate
4.3. Antagonistic Activity by Cell Suspension and Cell-Free Supernatant from Isolate
4.4. Field Study
4.5. Effect of Bioformulation on Biochemical Aspects of S. rebaudiana
4.6. Estimation of Stevioside Content
4.7. Effect of P-WBF on Nutrient Uptake in Stevia Plants
4.8. Quantitative Analysis of UGT85C2, UGT74G1, and UGT76G1 Genes in Steviol Glycoside Biosynthesis by RT-qPCR
4.8.1. Plant Sample, Primer Designing, and Its Validation
4.8.2. RNA Extraction and cDNA Synthesis
4.8.3. Quantitative Analysis of UGT85C2, UGT74G1, and UGT76G1 Genes in Steviol Glycoside Biosynthesis Using RT-qPCR
4.9. Effect of Bioformulation on Soil Health
4.10. Experimental Statistical Analysis
5. Conclusions
Supplementary Materials
Author Contributions
Funding
Institutional Review Board Statement
Informed Consent Statement
Data Availability Statement
Acknowledgments
Conflicts of Interest
References
- Prakash, J.; Arora, N.K. Development of Bacillus safensis-based liquid bioformulation to augment growth, stevioside content, and nutrient uptake in Stevia rebaudiana. World J. Microbiol. Biotechnol. 2020, 36, 1–13. [Google Scholar] [CrossRef]
- Raspe, D.T.; da Silva, C.; da Costa, S.C. Compounds from Stevia rebaudiana Bertoni leaves: An overview of non-conventional extraction methods and challenges. Food Biosci. 2022, 22, 101593. [Google Scholar] [CrossRef]
- Ali, A.; Shahu, R.; Balyan, P.; Kumari, S.; Ghodmare, R.; Jobby, R.; Jha, P. Antioxidation and antiglycation properties of a natural sweetener: Stevia rebaudiana. Sugar Tech. 2022, 24, 563–575. [Google Scholar] [CrossRef]
- Latridis, N.; Kougioumtzi, A.; Vlataki, K.; Papadaki, S.; Magklara, A. Anti-Cancer Properties of Stevia rebaudiana; More than a Sweetener. Molecules 2022, 27, 1362–1375. [Google Scholar] [CrossRef] [PubMed]
- Gaweł-Bęben, K.; Bujak, T.; Nizioł-Łukaszewska, Z.; Antosiewicz, B.; Jakubczyk, A.; Karaś, M.; Rybczyńska, K. Stevia rebaudiana Bert. leaf extracts as a multifunctional source of natural antioxidants. Molecules 2015, 20, 5468–5486. [Google Scholar] [CrossRef] [PubMed] [Green Version]
- Azzam, C.R.; Al-Taweel, S.K.; Abdel-Aziz, R.M.; Rabea, K.M.; Abou-Sreea, A.I.; Rady, M.M.; Ali, E.F. Salinity effects on gene expression, morphological, and physio-biochemical responses of stevia rebaudiana bertoni in vitro. Plants 2021, 10, 820. [Google Scholar] [CrossRef]
- Ahmad, N.; Rab, A.; Sajid, M.; Ahmad, N.; Fazal, H.; Ali, M.; Egertsdotter, U. Sucrose-dependent production of biomass and low-caloric steviol glycosides in adventitious root cultures of Stevia rebaudiana (Bert.). Ind. Crops Prod. 2021, 164, 113382. [Google Scholar] [CrossRef]
- Lee, S.Y.; Shaari, K. LC–MS metabolomics analysis of Stevia rebaudiana Bertoni leaves cultivated in Malaysia in relation to different developmental stages. Phytochemical Anal. 2022, 33, 249–261. [Google Scholar] [CrossRef]
- Modi, A.; Litoriya, N.; Prajapati, V.; Rafalia, R.; Narayanan, S. Transcriptional profiling of genes involved in steviol glycoside biosynthesis in Stevia rebaudiana bertoni during plant hardening. Develop. Dynam. 2014, 243, 1067–1073. [Google Scholar] [CrossRef]
- Vazquez-Hernandez, C.; Feregrino-Perez, A.A.; Perez-Ramirez, I.; Ocampo-Velazquez, R.V.; Rico-García, E.; Torres-Pacheco, I.; Guevara-Gonzalez, R.G. Controlled elicitation increases steviol glycosides (SGs) content and gene expression-associated to biosynthesis of SGs in Stevia rebaudiana B. cv. Morita II. Ind. Crops Prod. 2019, 139, 111479–111483. [Google Scholar] [CrossRef]
- Ahmad, A.; Ali, H.; Khan, H.; Begam, A.; Khan, S.; Ali, S.S.; Abbasi, B.H. Effect of gibberellic acid on production of biomass, polyphenolics and steviol glycosides in adventitious root cultures of Stevia rebaudiana (Bert.). Plants 2020, 9, 420. [Google Scholar] [CrossRef] [Green Version]
- Sarmiento-López, L.G.; López-Meyer, M.; Sepúlveda-Jiménez, G.; Cárdenas, L.; Rodríguez-Monroy, M. Photosynthetic performance and stevioside concentration are improved by the arbuscular mycorrhizal symbiosis in Stevia rebaudiana under different phosphate concentrations. Peer J. 2020, 8, e10173. [Google Scholar] [CrossRef]
- Bandyopadhyay, P.; Yadav, B.G.; Kumar, S.G.; Kumar, R.; Kogel, K.H.; Kumar, S. Piriformospora indica and Azotobacter chroococcum Consortium Facilitates Higher Acquisition of N, P with Improved Carbon Allocation and Enhanced Plant Growth in Oryza sativa. J. Fungi 2022, 8, 453–462. [Google Scholar] [CrossRef]
- Mandal, P.; Tiru, Z. Soil Application of Plant Growth Promoting Fungi for Sustainable Agriculture in the New Decade. In Plant Stress: Challenges and Management in the New Decade; Springer: Berlin/Heidelberg, Germany, 2022; Volume 32, pp. 321–330. [Google Scholar] [CrossRef]
- Prakash, J.; Arora, N.K. Novel metabolites from Bacillus safensis and their antifungal property against Alternaria alternata. Antonie Van Leeuwenhoek 2021, 4, 1–14. [Google Scholar] [CrossRef]
- Meena, M.; Swapnil, P.; Upadhyay, R.S. Isolation, characterization and toxicological potential of Alternaria-mycotoxins (TeA, AOH and AME) in different Alternaria species from various regions of India. Sci. Rep. 2017, 7, 1–19. [Google Scholar] [CrossRef] [Green Version]
- Bashan, Y.; Prabhu, S.R.; de-Bashan, L.E.; Kloepper, J.W. Disclosure of exact protocols of fermentation, identity of microorganisms within consortia, formation of advanced consortia with microbe-based products. Biol. Fertil. Soils 2020, 56, 443–445. [Google Scholar] [CrossRef]
- Mishra, J.; Prakash, J.; Arora, N.K. Role of beneficial soil microbes in sustainable agriculture and environmental management. Climate Change Environ. Sustain. 2016, 4, 137–149. [Google Scholar] [CrossRef]
- Prakash, J.; Arora, N.K. Phosphate-solubilizing Bacillus sp. enhances growth, phosphorus uptake and oil yield of Mentha arvensis L. 3 Biotech. 2019, 9, 126. [Google Scholar] [CrossRef]
- Wang, S.; Sun, L.; Zhang, W.; Chi, F.; Hao, X.; Bian, J.; Li, Y. Bacillus velezensis BM21, a potential and efficient biocontrol agent in control of corn stalk rot caused by Fusarium graminearum. Egypt. J. Biolog. Pest Contr. 2020, 30, 9–20. [Google Scholar] [CrossRef]
- Gao, X.; Guo, H.; Zhang, Q.; Guo, H.; Zhang, L.; Zhang, C.; Gou, Z.; Liu, Y.; Wei, J.; Chen, A.; et al. Arbuscular mycorrhizal fungi (AMF) enhanced the growth, yield, fiber quality and phosphorus regulation in upland cotton (Gossypium hirsutum L.). Sci. Rep. 2020, 10, 1–12. [Google Scholar] [CrossRef] [Green Version]
- Bennett, A.E.; Groten, K. The Costs and Benefits of Plant–Arbuscular Mycorrhizal Fungal Interactions. Annu. Rev. Plant Biol. 2022, 23, 73–85. [Google Scholar] [CrossRef] [PubMed]
- Pickles, B.J.; Truong, C.; Watts-Williams, S.J.; Bueno, C.G. Mycorrhizas for a sustainable world. New Phytol. 2020, 225, 1065–1069. [Google Scholar] [CrossRef] [PubMed] [Green Version]
- Singh, P.; Singh, R.K.; Zhou, Y.; Wang, J.; Jiang, Y.; Shen, N.; Jiang, M. Unlocking the strength of plant growth promoting Pseudomonas in improving crop productivity in normal and challenging environments: A review. J. Plant Inter. 2022, 17, 220–238. [Google Scholar] [CrossRef]
- Kang, S.M.; Radhakrishnan, R.; Lee, I.J. Bacillus amyloliquefaciens subsp. plantarum GR53, a potent biocontrol agent resists Rhizoctonia disease on Chinese cabbage through hormonal and antioxidants regulation. World J. Microbiol. Biotechnol. 2015, 31, 1517–1527. [Google Scholar] [CrossRef]
- El-Garhy, H.A.; Abdel-Rahman, F.A.; Shams, A.S.; Osman, G.H.; Moustafa, M.M. Comparative analyses of four chemicals used to control black mold disease in tomato and its effects on defense signaling pathways, productivity and quality traits. Plants 2020, 9, 808. [Google Scholar] [CrossRef]
- Kumar, M.; Brar, A.; Yadav, M.; Chawade, A.; Vivekanand, V.; Pareek, N. Chitinases-potential candidates for enhanced plant resistance towards fungal pathogens. Agriculture 2018, 8, 88–102. [Google Scholar] [CrossRef] [Green Version]
- Wang, C.; Thielemann, L.; Dippold, M.A.; Guggenberger, G.; Kuzyakov, Y.; Banfield, C.C.; Dorodnikov, M. Can the reductive dissolution of ferric iron in paddy soils compensate phosphorus limitation of rice plants and microorganisms? Soil Biol. Biochem. 2022, 168, 108653. [Google Scholar] [CrossRef]
- Kumar, M.; Dangayach, P.; Pareek, N. Enhanced glucosamine production through synergistic action of Aspergillus terreus chitozymes. J. Cleaner Prod. 2020, 262, 121363. [Google Scholar] [CrossRef]
- Behera, B.C.; Sethi, B.K.; Mishra, R.R.; Dutta, S.K.; Thatoi, H.N. Microbial cellulase–Diversity & biotechnology with reference to mangrove environment: A review. J. Gen. Eng. Biotechnol. 2017, 15, 197–210. [Google Scholar] [CrossRef]
- Chen, Y.; Xu, H.; Zhou, M.; Wang, Y.; Wang, S.; Zhang, J. Salecan enhances the activities of β-1, 3-glucanase and decreases the biomass of soil-borne fungi. PLoS ONE 2015, 10, 15–28. [Google Scholar] [CrossRef]
- Mia, M.A. Enhanced Root Morphogenesis in Non-legumes as Induced by Rhizobacteria Bacillus spp. In Bacilli in Agrobiotechnology; Springer: Cham, Switzerland, 2022; Volume 1, pp. 151–168. [Google Scholar] [CrossRef]
- Abdelmoteleb, A.; Troncoso-Rojas, R.; Gonzalez-Soto, T.; González-Mendoza, D. Antifungical activity of autochthonous Bacillus subtilis isolated from Prosopis juliflora against phytopathogenic fungi. Mycobiology 2017, 45, 385–391. [Google Scholar] [CrossRef] [Green Version]
- Jorjani, M.; Heydari, A.; Zamanizadeh, H.R.; Rezaee, S.; Naraghi, L. Development of Pseudomonas fluorescens and Bacillus coagulans based bioformulations using organic and inorganic carriers and evaluation of their influence on growth parameters of sugar beet. J. Biopest. 2011, 4, 180–195. [Google Scholar]
- Farhaoui, A.; Adadi, A.; Tahiri, A.; El Alami, N.; Khayi, S.; Mentag, R.; Lahlali, R. Biocontrol potential of plant growth-promoting rhizobacteria (PGPR) against Sclerotiorum rolfsii diseases on sugar beet (Beta vulgaris L.). Physiol. Mol. Plant Pathol. 2022, 119, 101829. [Google Scholar] [CrossRef]
- Sardar, H.; Nisar, A.; Anjum, M.A.; Naz, S.; Ejaz, S.; Ali, S.; Ahmad, R. Foliar spray of moringa leaf extract improves growth and concentration of pigment, minerals and stevioside in stevia (Stevia rebaudiana Bertoni). Ind. Crops Prod. 2021, 166, 113485. [Google Scholar] [CrossRef]
- Kumar, A.; Singh, M.; Singh, P.P.; Singh, S.K.; Singh, P.K.; Pandey, K.D. Isolation of plant growth promoting rhizobacteria and their impact on growth and curcumin content in Curcuma longa L. Biocat. Agri. Biotech. 2016, 8, 1–7. [Google Scholar] [CrossRef]
- Ghosh, S.K.; Banerjee, S.; Pal, S.; Chakraborty, N. Encountering epidemic effects of leaf spot disease (Alternaria brassicae) on Aloe vera by fungal biocontrol agents in agrifields: An ecofriendly approach. PLoS ONE 2018, 13, 15–32. [Google Scholar] [CrossRef] [Green Version]
- Mangwende, E.; Kritzinger, Q.; Aveling, T.A.S. Control of Alternaria leaf spot of coriander in organic farming. Eur. J. Plant Pathol. 2019, 154, 575–584. [Google Scholar] [CrossRef]
- Gorain, B.; Paul, S.; Parihar, M. Role of soil microbes in micronutrient solubilization. In New and Future Developments in Microbial Biotechnology and Bioengineering; Elsevier: Amsterdam, The Netherlands, 2022; pp. 131–150. [Google Scholar] [CrossRef]
- Zheng, J.; Zhuang, Y.; Mao, H.Z.; Jang, I.C. Overexpression of SrDXS1 and SrKAH enhances steviol glycosides content in transgenic Stevia plants. BMC Plant Biol. 2019, 19, 1–15. [Google Scholar] [CrossRef]
- Kumar, H.; Kaul, K.; Bajpai-Gupta, S.; Kaul, V.K.; Kumar, S. A comprehensive analysis of fifteen genes of steviol glycosides biosynthesis pathway in Stevia rebaudiana (Bertoni). Gene 2012, 492, 276–284. [Google Scholar] [CrossRef]
- Nieves-Cordones, M.; Martínez, V.; Benito, B.; Rubio, F. Comparison between Arabidopsis and rice for main pathways of K+ and Na+ uptake by roots. Front. Plant Sci. 2016, 7, 992. [Google Scholar] [CrossRef] [Green Version]
- Saleem, S.; Khan, S.T. Development of Microbes-Based Biofertilizer for Zinc Dissolution in Soil. In Microbial Biofertilizers and Micronutrient Availability; Springer: Berlin/Heidelberg, Germany, 2022; pp. 299–329. [Google Scholar] [CrossRef]
- Prakash, J.; Arora, N. Novel Metabolites Identified From Bacillus Safensis and Their Antifungal Property Against Alternaria Alternata. Antonie Van Leeuwenhoek 2021, 14, 1245–1258. [Google Scholar] [CrossRef]
- Bakker, A.W.; Schippers, B. Microbial cyanide production in the rhizosphere in relation to potato yield reduction and Pseudomonas spp-mediated plant growth-stimulation. Soil Biol. Biochem. 1987, 19, 451–457. [Google Scholar] [CrossRef]
- Meyer, J.A.; Abdallah, M.A. The fluorescent pigment of Pseudomonas fluorescens: Biosynthesis, purification and physicochemical properties. Microbiology 1978, 107, 319–328. [Google Scholar] [CrossRef] [Green Version]
- Lim, H.; Kim, Y.; Kim, S. Pseudomonas stutzeri YLP-1 genetic transformation and antifungal mechanism against Fusarium solani, an agent of plant root rot. Appl. Environ. Microbiol. 1991, 57, 5–16. [Google Scholar] [CrossRef] [Green Version]
- Ghose, T.K.; Montenecourt, B.S.; Eveleigh, D.E. Commission of biotechnology, measurement of cellulase activities. Pure Appl. Chem. 1987, 59, 257–268. [Google Scholar] [CrossRef]
- Soria, M.C.; Audisio, M.C. Inhibition of Bacillus cereus strains by antimicrobial metabolites from Lactobacillus johnsonii CRL1647 and Enterococcus faecium SM21. Probio. Anti. Prot. 2014, 6, 208–216. [Google Scholar] [CrossRef]
- Tewari, S.; Arora, N.K. Multifunctional exopolysaccharides from Pseudomonas aeruginosa PF23 involved in plant growth stimulation, biocontrol and stress amelioration in sunflower under saline conditions. Cur. Microbiol. 2014, 69, 484–494. [Google Scholar] [CrossRef]
- Mandal, S.; Upadhyay, S.; Singh, V.P.; Kapoor, R. Enhanced production of steviol glycosides in mycorrhizal plants: A concerted effect of arbuscular mycorrhizal symbiosis on transcription of biosynthetic genes. Plant Physiol. Biochem. 2015, 89, 100–106. [Google Scholar] [CrossRef]
- Albalasmeh, A.A.; Berhe, A.A.; Ghezzehei, T.A. A new method for rapid determination of carbohydrate and total carbon concentrations using UV spectrophotometry. Carbohydr. Poly. 2013, 97, 253–261. [Google Scholar] [CrossRef]
- Lowry, O.H.; Rosebrough, N.J.; Farr, A.L.; Randall, R.J. Protein measurement with the Folin phenol reagent. J. Biolog. Chem. 1951, 193, 265–275. [Google Scholar] [CrossRef]
- Arnon, D.I. Copper enzymes in isolated chloroplasts: Polyphenoloxidase in Beta vulgaris. Plant Physiol. 1949, 24, 1–15. [Google Scholar] [CrossRef] [PubMed] [Green Version]
- Braca, A.; De Tommasi, N.; Di, B.L.; Pizza, C.; Politi, M.; Morelli, I. Antioxidant principles from bauhinia t arapotensis. J. Natur. Prod. 2001, 64, 892–895. [Google Scholar] [CrossRef] [PubMed]
- Quettier-Deleu, C.; Gressier, B.; Vasseur, J.; Dine, T.; Brunet, C.; Luyckx, M.; Cazin, M.; Cazin, J.C.; Bailleul, F.; Trotin, F. Phenolic compounds and antioxidant activities of buckwheat (Fagopyrum esculentum Moench) hulls and flour. J. Ethnopharmacol. 2000, 72, 35–42. [Google Scholar] [CrossRef]
- Rai, C.; Majumdar, G.C.; De, S. Optimization of process parameters for water extraction of stevioside using response surface methodology. Sep. Sci. Technol. 2012, 47, 1014–1022. [Google Scholar] [CrossRef]
- Rahi, P.; Pathania, V.; Gulati, A.; Singh, B.; Bhanwra, R.K.; Tewari, R. Stimulatory effect of phosphate-solubilizing bacteria on plant growth, stevioside and rebaudioside-A contents of Stevia rebaudiana Bertoni. Appl. Soil Ecol. 2010, 46, 222–229. [Google Scholar]
- Koenig, R.; Johnson, C. Colorimetric determination of phosphorus in biological materials. Ind. Eng. Chem. Anal. 1942, 14, 155–156. [Google Scholar] [CrossRef]
- Horwitz, W.; Chichilo, P.; Reynolds, H. Official methods of analysis of the association of official analytical chemists. J. Am. Oil Chem. Society 1970, 54, 171–172. [Google Scholar]
- Jackson, M.L. Soil Chemical Analysis; Prentice Hall India Pvt. Ltd.: New Delhi, India, 1967; 498p. [Google Scholar]
- Ghawana, S.; Paul, A.; Kumar, H.; Kumar, A.; Singh, H.; Bhardwaj, P.K.; Rani, A.; Singh, R.S.; Raizada, J.; Singh, K.; et al. An RNA isolation system for plant tissues rich in secondary metabolites. BMC Res. Notes 2011, 4, 85–89. [Google Scholar] [CrossRef] [Green Version]
- Radonić, A.; Thulke, S.; Mackay, I.M.; Landt, O.; Siegert, W.; Nitsche, A. Guideline to reference gene selection for quantitative real-time PCR. Biochem. Biophy. Res. Commun. 2004, 313, 856–862. [Google Scholar] [CrossRef]
- Grewal, K.S.; Buchan, G.D.; Sherlock, R.R. A comparison of three methods of organic carbon determination in some New Zealand soils. J. Soil Sci. 1991, 42, 251–257. [Google Scholar] [CrossRef]
- Taylor, M.D. Determination of total phosphorus in soil using simple Kjeldahl digestion. Commun. Soil Sci. Plant Anal. 2000, 31, 2665–2670. [Google Scholar] [CrossRef]
- Subbiah, B.V.; Asija, G.L. A rapid method for the estimation of nitrogen in soil. Cur. Sci. 1956, 26, 259–260. [Google Scholar]
- Gomez, K.A.; Gomez, A.A. Duncan’s multiple Range test. Statistical Proced. Agri. Res. 1984, 2, 540–544. [Google Scholar]
- Compton, M.E. Statistical method suitable for the analysis of plant tissue culture data. Plant Cell Tissue Organ Cult. 1994, 37, 217–242. [Google Scholar] [CrossRef]

| Treatments | Growth Parameters of S. rebaudiana after Application of P-WBF and Mycorrhiza (30 Days) | ||||||
|---|---|---|---|---|---|---|---|
| Plant Length (cm) | Number of Leaves | Fresh Weight (gm) | Dry Weight (gm) | ||||
| Shoot Length | Root Length | - | Shoot | Root | Shoot | Root | |
| Control | 13.30 ± 2.28 d | 3.20 ± 0.56 d | 45.66 ± 2.10 d | 20.10 ± 1.24 d | 5.24 ± 0.86 d | 9.30 ± 0.86 d | 2.10 ± 0.04 d |
| P-WBF | 22.50 ± 2.21 b | 5.00 ± 1.02 a | 85.00 ± 2.14 b | 35.24 ± 2.40 b | 8.62 ± 0.96 a | 12.45 ± 1.24 b | 5.00 ± 0.05 b |
| Mycorrhiza | 18.30 ± 2.45 c | 5.10 ± 0.28 c | 80.42 ± 2.36 c | 26.42 ± 1.42 c | 6.86 ± 0.80 c | 10.24 ± 1.12 c | 4.20 ± 0.70 c |
| P-WBF + Mycorrhiza | 28.83 ± 2.04 a | 5.14 ± 1.60 ab | 90.66 ± 4.12 a | 40.12 ± 1.24 a | 8.44 ± 0.94 ab | 14.20 ± 1.60 a | 6.20 ± 1.02 a |
| Growth Parameters of S. rebaudiana after Application of P-WBF and Mycorrhiza (60 days) | |||||||
| Plant Length (cm) | Number of Leaves | Fresh Weight (gm) | Dry Weight (gm) | ||||
| Shoot Length | Root Length | - | Shoot | Root | Shoot | Root | |
| Control | 18.08 ± 1.78 d | 4.32 ± 0.86 d | 85.33 ± 2.84 d | 35.72 ± 2.60 d | 7.46 ± 0.86 d | 15.10 ± 2.20 d | 3.98 ± 0.86 d |
| P-WBF | 31.60 ± 4.48 b | 6.80 ± 2.46 b | 152.46 ± 2.80 b | 58.46 ± 2.45 b | 10.24 ± 0.48 b | 26.10 ± 1.24 b | 8.62 ± 0.80 ab |
| Mycorrhiza | 28.63 ± 4.56 c | 5.96 ± 0.80 c | 142.0 ± 4.24 bc | 51.84 ± 2.45 c | 9.52 ± 0.48 c | 22.50 ± 1.10 c | 7.62 ± 0.54 c |
| P-WBF + Mycorrhiza | 36.34 ± 5.45 a | 7.24 ± 1.89 a | 164.88 ± 5.24 a | 62.34 ± 2.47 a | 12.54 ± 1.14 a | 30.12 ± 3.24 a | 8.96 ± 1.21 a |
| Growth Parameters of S. rebaudiana after Application of P-WBF and Mycorrhiza (90 days) | |||||||
| Plant Length (cm) | Number of Leaves | Fresh Weight (gm) | Dry Weight (gm) | ||||
| Shoot Length | Root Length | - | Shoot | Root | Shoot | Root | |
| Control | 23.43 ± 4.25 d | 5.90 ± 1.14 d | 135.44 ± 6.10 d | 62.45 ± 2.84 d | 9.64 ± 1.12 d | 25.36 ± 2.12 d | 5.96 ± 0.98 d |
| P-WBF | 40.26 ± 4.15 b | 8.20 ± 1.50 b | 224.18 ± 6.88 b | 118.42 ± 4.42 b | 20.56 ± 1.48 b | 60.12 ± 3.46 b | 12.24 ± 2.24 b |
| Mycorrhiza | 30.12 ± 2.46 c | 7.00 ± 0.84 c | 180.60 ± 6.50 c | 74.52 ± 1.86 cd | 12.54 ± 0.84 c | 50.24 ± 2.42 c | 10.58 ± 1.70 c |
| P-WBF + Mycorrhiza | 58.46 ± 4.46 a | 9.1 ± 2.42 a | 245.45 ± 5.20 a | 142.46 ± 4.86 a | 24.89 ± 1.88 a | 74.56 ± 4.56 a | 14.46 ± 1.12 a |
| Treatments | Potassium Content (mg/plant) | Phosphorus Content (mg/plant) | Zinc Content (mg/plant) |
|---|---|---|---|
| Control | 3.21 ± 0.07 d | 129.01 ± 6.84 d | 1.08 ± 0.08 d |
| P-WBF | 6.01 ± 0.41 b | 221.28 ± 5.76 b | 2.12 ± 0.10 b |
| Mycorrhiza | 4.32 ± 0.63 c | 160.48 ± 5.68 c | 1.60 ± 0.10 c |
| P-WBF + Mycorrhiza | 7.46 ± 0.30 a | 250.57 ± 12.79 a | 2.28 ± 0.04 a |
Publisher’s Note: MDPI stays neutral with regard to jurisdictional claims in published maps and institutional affiliations. |
© 2022 by the authors. Licensee MDPI, Basel, Switzerland. This article is an open access article distributed under the terms and conditions of the Creative Commons Attribution (CC BY) license (https://creativecommons.org/licenses/by/4.0/).
Share and Cite
Prakash, J.; Egamberdieva, D.; Arora, N.K. A Novel Bacillus safensis-Based Formulation along with Mycorrhiza Inoculation for Controlling Alternaria alternata and Simultaneously Improving Growth, Nutrient Uptake, and Steviol Glycosides in Stevia rebaudiana under Field Conditions. Plants 2022, 11, 1857. https://doi.org/10.3390/plants11141857
Prakash J, Egamberdieva D, Arora NK. A Novel Bacillus safensis-Based Formulation along with Mycorrhiza Inoculation for Controlling Alternaria alternata and Simultaneously Improving Growth, Nutrient Uptake, and Steviol Glycosides in Stevia rebaudiana under Field Conditions. Plants. 2022; 11(14):1857. https://doi.org/10.3390/plants11141857
Chicago/Turabian StylePrakash, Jai, Dilfuza Egamberdieva, and Naveen Kumar Arora. 2022. "A Novel Bacillus safensis-Based Formulation along with Mycorrhiza Inoculation for Controlling Alternaria alternata and Simultaneously Improving Growth, Nutrient Uptake, and Steviol Glycosides in Stevia rebaudiana under Field Conditions" Plants 11, no. 14: 1857. https://doi.org/10.3390/plants11141857
APA StylePrakash, J., Egamberdieva, D., & Arora, N. K. (2022). A Novel Bacillus safensis-Based Formulation along with Mycorrhiza Inoculation for Controlling Alternaria alternata and Simultaneously Improving Growth, Nutrient Uptake, and Steviol Glycosides in Stevia rebaudiana under Field Conditions. Plants, 11(14), 1857. https://doi.org/10.3390/plants11141857

